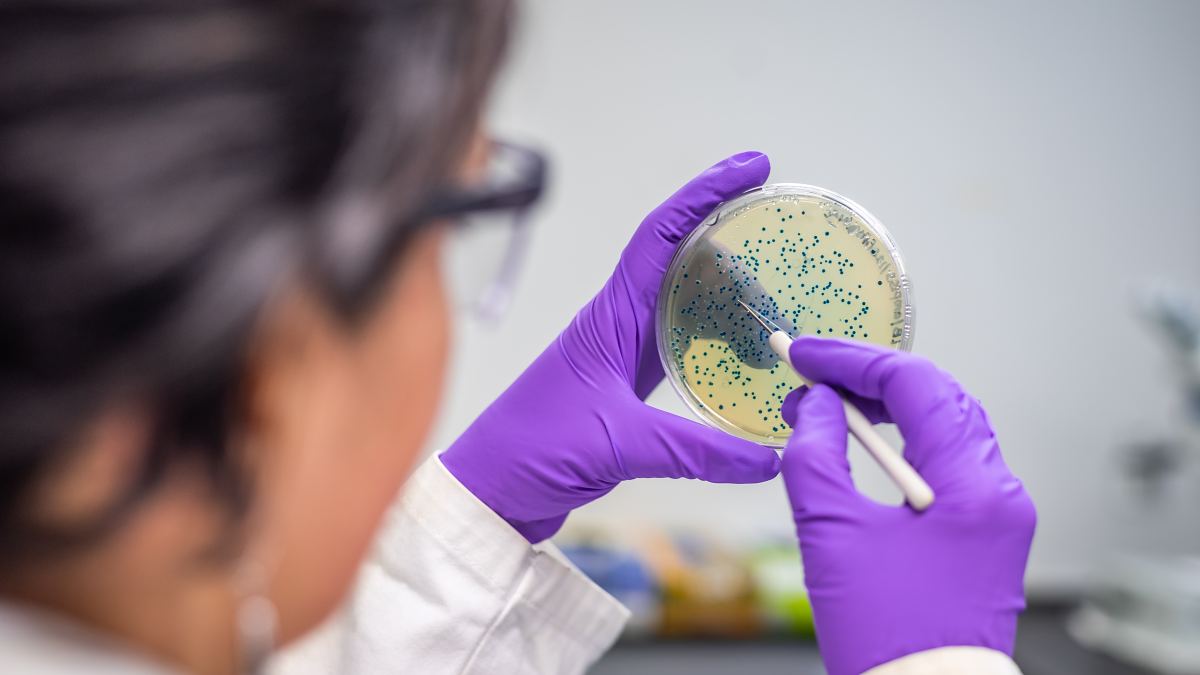

Vědci z olomouckého ústavu Catrin společně se švýcarskými odborníky vyvinuli speciální povlak, který by měl zajistit jednoduché usmrcení bakterií a virů. Jeho antimikrobiální účinek lze jednoduše aktivovat infračerveným světlem. Materiál je šetrný k pokožce i životnímu prostředí a může se podle nich stát zbraní v boji proti bakteriím odolným vůči antibiotikům. První praktické využití se připravuje ve stomatologii, sdělili ČTK zástupci Univerzity Palackého v Olomouci, pod kterou ústav Catrin spadá. Na výzkumu se podíleli také odborníci z Vysoké školy báňské-Technické univerzity Ostrava.
Ekologicky šetrný a biokompatibilní nový materiál bez přítomnosti kovů má za úkol likvidovat mikroorganismy rychle a lokálně. Jeho základem je polyvinylalkohol – biokompatibilní plast běžně používaný například v potravinářství. „Do této matrice byla začleněna speciálně syntetizovaná, dusíkem obohacená grafenová kyselina, která má díky svým chemickým vlastnostem výrazný antimikrobiální potenciál. Plný účinek se projeví při ozáření blízkým infračerveným světlem,“ uvedl Radek Zbořil, který se na výzkumu podílel. Materiál podle něj uplatňuje dvojí strategii – přeměňuje světelnou energii na teplo, které ničí bakterie, zároveň však také vytváří kyslíkové radikály, jež narušují membrány patogenů.
Rezistence bakterií
Výhodou tohoto přístupu podle něj je, že se zcela liší od mechanismu účinku klasických antibiotik. Materiál tak chrání proti širokému spektru mikroorganismů, aniž by přispíval k rozvoji rezistence. „Naše laboratorní testy jednoznačně potvrdily účinnost materiálu proti bakteriím i virům. Zejména povrchy, které přicházejí do častého kontaktu s infekčními původci, například kliky dveří v nemocnicích nebo vybavení operačních sálů, jsou ideální pro využití těchto inovací,“ doplnil Giacomo Reina ze švýcarského centra EMPA.
První praktické použití nového povlaku se připravuje pro zubní lékařství. Švýcarští vědci spolupracují s Centrem zubní medicíny Univerzity v Curychu na vývoji zubní dlahy s pevně ukotvenou grafenovou kyselinou. Díky tomu, že blízké infračervené světlo proniká tkání až několik centimetrů hluboko, lze dlahu umístit do úst, opakovaně aktivovat vnějším světelným zdrojem a zničit mikroorganismy v ústech, kde je mikroflóra obzvlášť odolná. Složité bakteriální komunity se totiž ukrývají v těžko dostupných zákoutích, chráněné vrstvou vlastního hlenu. „Antibiotika a běžné dezinfekce do těchto biofilmů pronikají jen velmi obtížně. To umožňuje bakteriím ničit zuby, nebo dokonce způsobovat vážné infekce jinde v těle,“ dodali zástupci projektu. Upozornili přitom, že bakterie odolné vůči antibiotikům a nové viry představují stále vážnější hrozbu pro globální zdravotní systém.